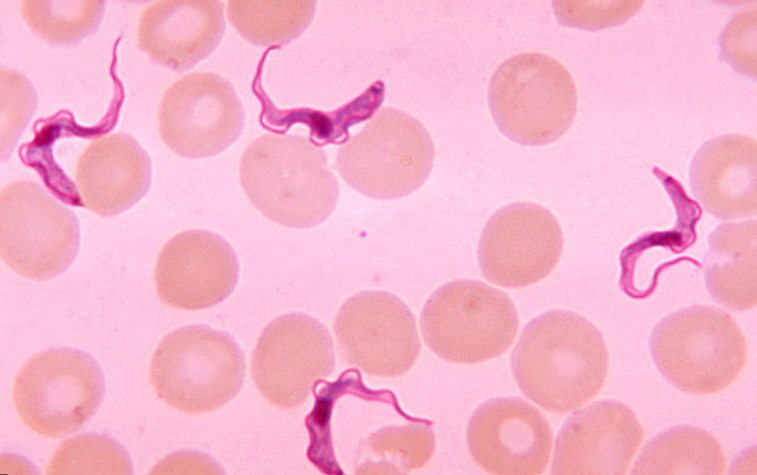
term image
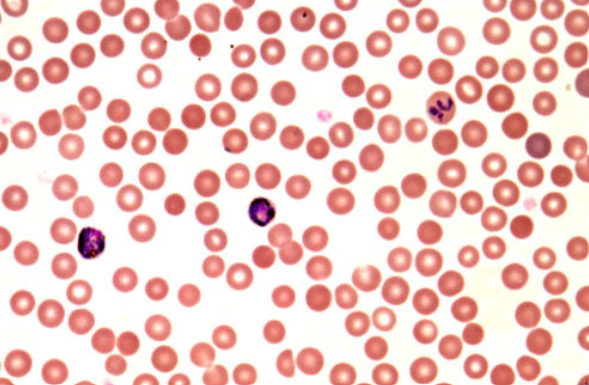
term image

Zoo Lab Final
1/100
There's no tags or description
Looks like no tags are added yet.
Name | Mastery | Learn | Test | Matching | Spaced | Call with Kai |
|---|
No analytics yet
Send a link to your students to track their progress
101 Terms

Paramecium → Phylum Ciliophora

Entomobea histolytica
causes amoebic dysentery
phylum Ameobozoa → subphylum lobozoa → class Archamobea
Trypanosoma
causes sleeping sickness
Phylum Euglenozoa → class Kinoplastida

Foraminifera
external tests with pseudopodia extending through pores

Radiozoa
rigid exoskeleton with axopodia supported by microtubules

Stentor
Phylum ciliophora → class Heterotrichea
Plasmodium vivax
causes malaria
phylum apicomplexa → class aconoidasida

Amoeba proteus
phylum amebozoa → class tubulinea → order euamoebida

Spicules
made by sclerocytes
composed of silica or calcium carbonate

Gemmules
used for asexual reproduction (dormant in unfavorable conditions)

osculum and spongocoel

incurrent canal, radial canal, and spongocoel
nematocyst
stinging cells

siphonoglyph, pharynx, tentacles

Planula Larva

scyphistoma larva

ephyrae

Obelia
phylum cnidaria → class obelia

Gonangium (left) and hydranth (right)

tentacles, pharynx, siphonoglyph, acontia, pedal disk

Turbellaria planaria

HYDRA SHOWING SPERMARIES

HYDRA SHOWING OVARIES AND TESTES
BUDDING

brain
eye
sensory lobe
ventrolateral nerve
intestine
pharynx
mouth

Fasicola hepatica (liver fluke)
phylum Platyhelminthes → class trematoda
Fasicola hepatica digestive system
incomplete
highly branched
adapted for feeding on bile, tissue, and blood of host

gastrodermis
branches of digestive track
circular muscles
epidermis
dorsoventral muscles

hooks
rostellum
suckers

class cestoda (tapeworm)

Clonorchis sinensis (oriental liver fluke)
class cestoda

oral cavity
pharynx
intestine
ventral sucker
uterus
ovaries
seminal receptacle
testes
Clonorchis sinensis life cycle
intermediate snail host
miracidium differentiates into sprocytes
cercariae emerge from snail and burrow into fish
form metacercariae in muscle tissue of fish
infect people if fish improperly cooked
Fluke life cycle
Egg → Miracidium → Sporocyst → Redia → Cercaria → Mesocercaria (little modified) or Metacercaria (encysted) → Adult
Schistosoma
Blood fluke
class trematoda

Schistosoma haematobium
class trematoda

Planaria regeneration
class Turbellaria

Hydatid cyst of Echinococcus granulosus
Echinococcus granulosus life cycle
adult in small intestine → embryonated egg in feces ingested → oncosphere hatches and penetrates intestinal wall → hydatid cyst spreads through organs → protoscolex develops from cyst → scolex attaches to intestine → adult
sheep intermediate host (ingest egg in feces) → canine definitive host (ingest hydatid cyst from organs)

Trichuris (Whipworm)
Phylum Nematoda
Nematoda movement
whiplike fashion due to lack of circular muscle (only longitudinal)

Ascaris cross section
Phylum Nematoda

cuticle and hypodermis
longitudinal muscle
ovary
oviduct
uterus
intestine

cuticle and hypodermis
longitudinal muscle
vas deferens
testis
lateral line with excretory canal
intestine
Pseudocoelom

trochal disc
eye spots
brain
mastax
nephridia
germovitellarium
toes
Rotifera movement
swim - cilia of corona beat
creep - foot and toes

folded gill (ctenidium)

radula of snail (class gastropoda)

mussel glochidia larvae (parasitic)

Trochophore larva

shell
foot
velium

Veliger larva (free-swimming)

gills
anterior foot retractor
anterior adductor
posterior foot retractor
posterior adductor
foot
labial palps
mantle
nidamental glands
paired reproductive organs in cephalopods

Polychaetes (clamworms)

oligochaeta (earthworms)

Hirudinea (leeches)

Neris parapodium

superior ligula
aciculum
inferior ligula
neurochaeta

longitudinal muscle
typhlosole
lumen of intestine
circular muscle
subneural blood vessel
dorsal blood vessel
epidermis
coelom
seta
ventral blood vessel
ventral nerve cord

channel
crop
dorsoventral muscle
dermis
cecum
circular muscle
longitudinal muscle
epidermis
cuticle
setae
bristles/hairs on worms
chaetae
stiff bristles made of chitin
parapodia
lateral outgrowths on invertebrates
metameric segmentation
linear and serial repetition of homogenous body parts
clitellum
thick non-segmented section of oligochaetes
nephridia
excretory organs of annelids

nauplius larvae of barnacles

Cirripedia (barnacles)
subphylum crustacea

rostrum
aperture
capitulum
peduncle
somites
bilaterally paired blocks of paraxial mesoderm that form in the embryonic stage
Uniramous
single unbranched series of segments
biramous
forked/branched appendage

water flea (daphnia)

cyclops (copepods)

zoea larva of crabs

megalops larva of crab
who has mandibles
insecta, crustaceans, myriapods
who have antenna
insecta, crustaceans, myriapods

book lungs

honey bee stinger and poison sac

Cimex (bed bug)

human body louse

flea (insecta)

anopheles mosquito

pollen basket
pollen press

femur
trochanter
coxa
tibia
pretarus
tarus

hypopharynx
stipes
lacina
galea
palps
labium
ligula
mentum
maxilla
mandible
labrum
clypens

coxa
trochanter
femur
patella
tibia
metatarsus
tarsus

prosoma
opisothosoma
whipscorpion

frons, clypeus, labrum

telson
aculeus
opisthosoma
cephalothorax
chelicerae
pedipalps
walking legs
metasoma
scorpion (chelicerata)

stomach
anus
ampulla
radial canal
ring canal
mouth
digestive gland
echinoidea
sea urchins, mobile, stalked
asteroidea
sea stars, mobile, stalked
ophiuroidea
brittle stars, movile, stalked
crinoidea
sea lillies, sessile, unstalked
blastoidea
sea buds, sessile, unstalked

bipinnaria larva of sea stars (astroidea)

brachiolaria larva of sea stars (astroidea)

echinopluteus larva of sea urchins (echinoidea)